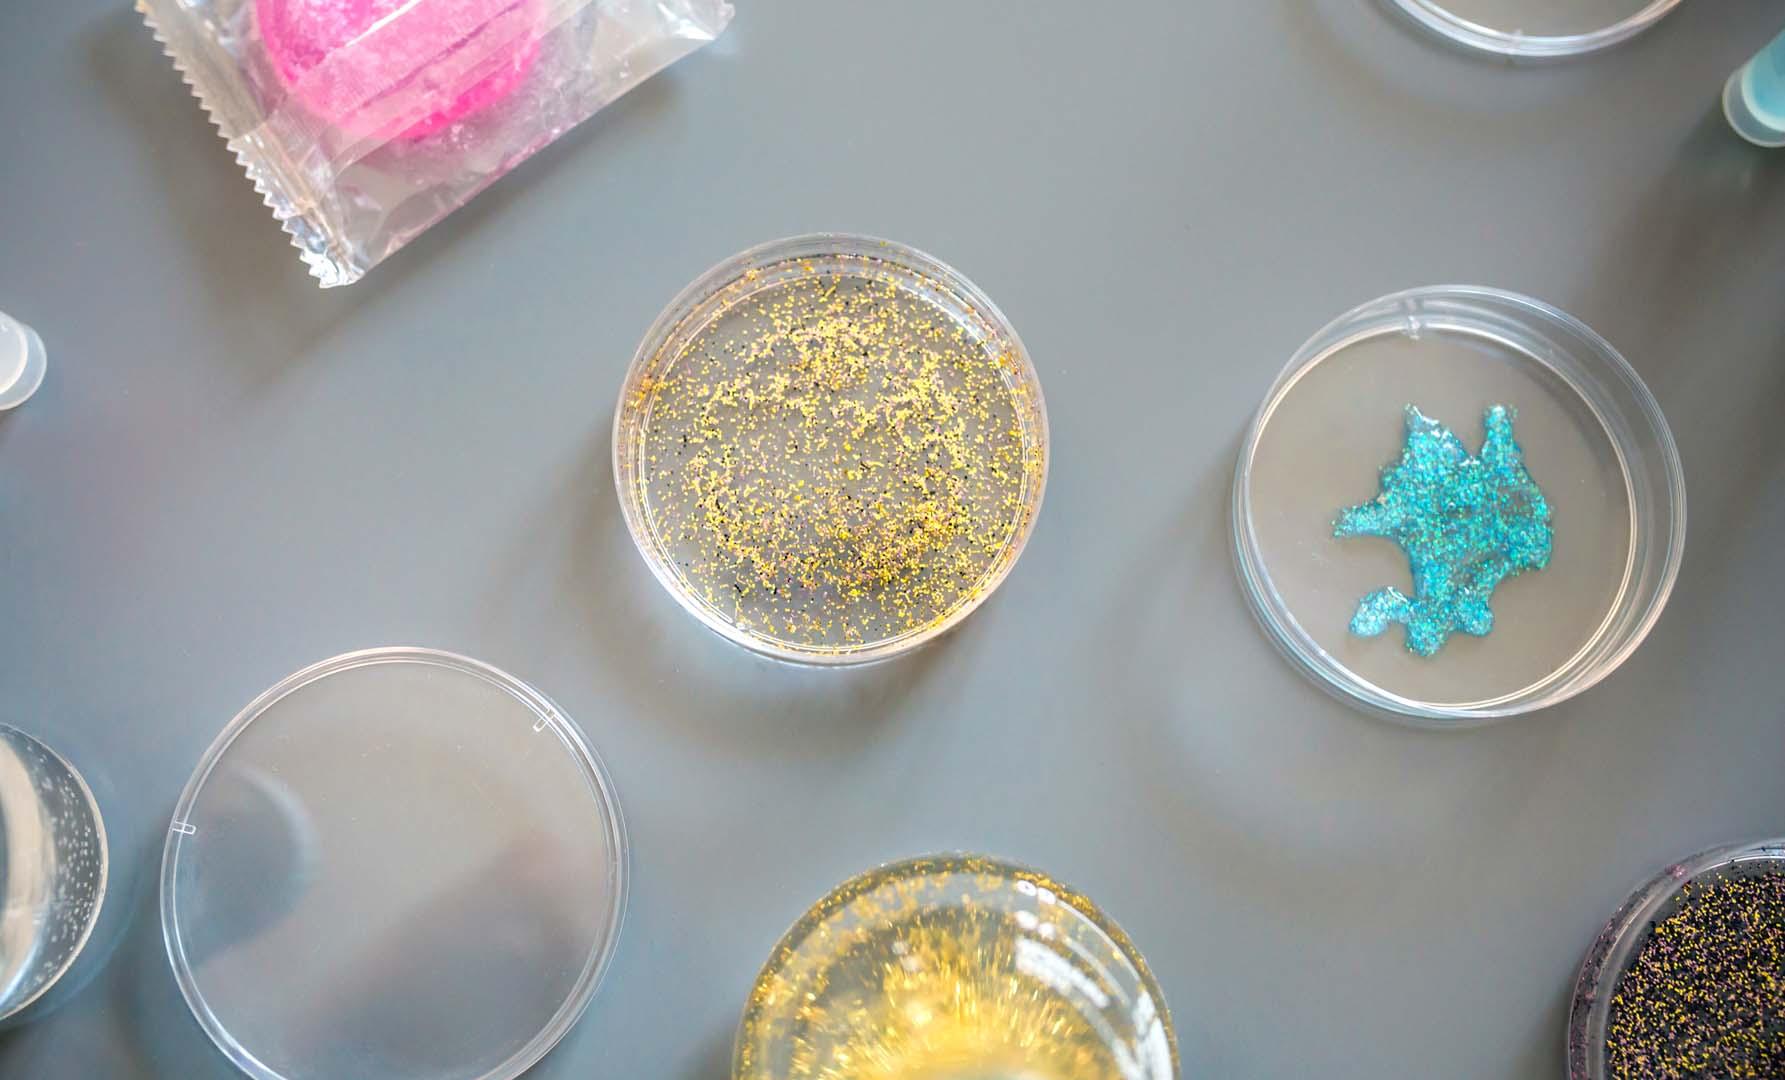

Günlük diyetinizdeki mikroplastiklerin 5 şaşırtıcı kaynağı
Beslenme uzmanları, yiyecek ve içeceklerden günlük olarak sıfırdan 1,5 milyon arasında mikroplastik parçacığı tüketebileceğimizi belirtiyorlar. Deniz ürünlerinin yanı sıra sakız, tuz, meyve-sebze ve sıcak içecekler de bu kontaminasyonun başlıca kaynakları arasında yer alıyor.
Halk, özellikle deniz ürünlerinde mikroplastik bulunabileceğini giderek daha iyi anlamaya başlasa da, bu tehlike aslında çok daha geniş bir yiyecek yelpazesinde yaygın olarak karşımıza çıkıyor. Bilimsel araştırmalar, her gün tükettiğimiz yiyecek ve içeceklerle vücudumuza giren mikroplastik miktarının oldukça yüksek olduğunu gösteriyor. Günlük mikroplastik alımı sıfırdan başlayarak 1,5 milyon parçacığa kadar çıkabiliyor. Bu kontaminasyonun en büyük kaynağının şişelenmiş su olduğu düşünülüyor, ancak diğer gıda ürünleri de önemli bir rol oynuyor.
Sakız çiğnerken plastik tüketiyorsunuz
Sakız çiğnediğiniz her an, esasen plastik ve kauçuk karışımından oluşan bir maddeyi ağzınıza alıyorsunuz. Çoğu sakız ürünü, plastikler ve kauçuktan yapılan bir sakız tabanından meydana gelir ve bu tabana tatlandırıcılar ile aroma maddeleri eklenir. Çiğneme işlemi sırasında, sakız tabanı mikroplastikleri serbest bırakır. Tek bir gram sakız, 637'ye kadar mikroplastik parçacık salabilir. Doğal kaynaklardan üretilen ve bitki polimerlerinden yapılan sakızlar da bu sorunu çözmüyor. Sentetik sakızla benzer miktarda mikroplastik salarlar. Bu bulgu, mikroplastiklerin sadece sakız tabanından kaynaklanmadığını, üretim veya paketleme aşamasında da giriş yapabileceğini gösteriyor. Araştırmalar, çoğu mikroplastik parçacığının çiğnemenin ilk sekiz dakikası içinde salındığını ortaya koymaktadır. Maruziyeti azaltmak istiyorsanız, sürekli yeni parçalar atmak yerine aynı sakız parçasını daha uzun süre çiğnemeyi tercih etmelisiniz.
Tuz ürünlerinde yaygın kontaminasyon
Tuz, saf ve basit bir bileşen gibi görünse de, dünya çapında yapılan araştırmalar oldukça endişe verici sonuçlar ortaya koymaktadır. Test edilen tuz ürünlerinin yüzde 94'ü mikroplastiklerle kontamine bulunmuştur. Bu kontaminasyon o kadar yaygındır ki, deniz tuzu, deniz ortamındaki mikroplastik kirliliğinin bir göstergesi olarak bile bilim insanları tarafından önerilmiştir. Dikkat çekici bir bulgu, kontaminasyonun deniz tuzlarından ziyade Himalaya tuzu gibi karasal tuzlarda daha yüksek seviyelerde olduğudur. Deniz tuzunu temizlemeye yardımcı olacak yeni teknolojiler araştırılmakta olsa da, kontaminasyonun çoğunun üretim ve paketleme süreçlerinden kaynaklandığı düşünülmektedir. Tuz değirmeni seçimi de bu sorunu ağırlaştırabiliyor. Tek kullanımlık plastik baharat değirmenleri, sadece 0,1 gram tuz öğütürken 7.628'e kadar parçacık salabilir. Maruziyeti en aza indirmek için seramik veya metal öğütme mekanizmasına sahip bir değirmene geçmek ve tuzu plastik olmayan kaplarda saklamak önerilmektedir.
Meyve ve sebzelerdeki nanoplastik riski
Meyve ve sebzelerin mikroplastik kontaminasyonu birkaç bilimsel çalışmada tespit edilmiştir. 1.000 nanometreden daha küçük olan nanoplastikler, bitkilerin köklerinden içeri girerek bitki dokularına yerleşebilir. Mikroplastikler ayrıca çeşitli meyve ve sebzelerin yüzeyinde de bulunmuştur. Yapılan bir çalışma, elmalar ve havuçların en yüksek kontaminasyon seviyesine sahip olduğunu, marulun ise en az kontamine olduğunu bulmuştur. Ancak, meyve ve sebzelerdeki mikroplastik kontaminasyonu, işlenmiş gıdalarla karşılaştırıldığında nispeten daha düşük seviyelerde kalmaktadır. Mikroplastiklerin insan sağlığı üzerindeki uzun vadeli etkilerini henüz tam olarak bilmesek de, meyve ve sebzelerin içerdiği antioksidanlar ve antosiyaninler gibi faydalı bileşenlerin sağlığımızı koruduğu bilinmektedir. Bu nedenle, meyve ve sebze tüketimini devam ettirmek önemlidir.
Sıcak içeceklerde yüksek mikroplastik seviyesi
Poşet çaylar, sıcak içeceğinize giren mikroplastiklerin tek kaynağı değildir. Çay yaprakları, kahve ve süt hepsi mikroplastiklerle kontamine olabilir. Tek kullanımlık plastik kaplı paket servis bardakların kullanımı, sıcak içeceklerdeki mikroplastik kontaminasyonunun en büyük kaynaklarından biridir. Yüksek sıcaklıklar, bardağın iç kaplamasından içeceğe mikroplastiklerin salınmasına neden olabilir. Sıcak içecekler, buzlu eşdeğerlerine kıyasla daha fazla mikroplastik içermektedir. Bu nedenle soğuk bir içeceğe geçmek maruziyeti azaltabilir. Sütü cam şişelerde satın almanın da daha düşük bir mikroplastik yüküyle sonuçlandığı gösterilmiştir. Ancak bu durum tüm içeceklere uygulanmaz. Yapılan bir araştırma, cam şişelerde saklanan alkolsüz içeceklerin ve biranın, muhtemelen boyalı metal şişe kapaklarından kontaminasyon nedeniyle, plastik şişelerden daha yüksek mikroplastik seviyesine sahip olduğunu ortaya koymaktadır. Gerçekten plastiksiz birkaç poşet çay mevcut olup, bu ürünler torbalarını kapatmak için biyolojik olarak parçalanabilir plastikler yerine pamuk kullanmaktadırlar. Ancak bu markaları belirlemek zor olabilir çünkü etiketlemede standart bir yaklaşım yoktur ve tüm şirketler ürünlerinin bileşimi konusunda şeffaf değildir. Genel olarak, dökme çaya geçmek ve metal veya cam yeniden kullanılabilir bardaklar kullanmak, mikroplastik kontaminasyonunu azaltmak için etkili stratejilerdir.
Deniz ürünlerinin gerçek riski
Çalışmalar, çoğu deniz ürününün mikroplastiklerle kontamine olduğunu göstermişse de, deniz ürünleri hakkında belki de en şaşırtıcı olan, diğer gıda kaynaklarına kıyasla aldığı ilgi miktarıdır. Yapılan bir araştırma, midye gibi sözde filtre besleyicilerde mikroplastik seviyelerinin gram başına sadece 0,2 ile 0,70 mikroplastik parçacığı arasında olduğunu göstermiştir. Bu miktar, plastik bir poşet çayla tek bir fincan çay demlerken salınan 11,6 milyar mikroplastikten önemli ölçüde daha azdır. Bu karşılaştırma, deniz ürünlerinin mikroplastik kontaminasyonunun, kamuoyunun algısından çok daha düşük olduğunu göstermektedir.
Sonuç olarak, mikroplastik kontaminasyonu sadece deniz ürünleriyle sınırlı değildir. Günlük beslenme alışkanlıklarımızda yer alan sakız, tuz, meyve-sebze ve sıcak içecekler de bu soruna önemli ölçüde katkıda bulunmaktadır. Maruziyeti azaltmak için bilinçli seçimler yapmak, doğru ürün seçimi ve depolama yöntemleri kullanmak mümkündür. Şişelenmiş su yerine musluk suyu tercih etmek, dökme çay kullanmak, metal veya seramik değirmenleri tercih etmek ve yeniden kullanılabilir bardaklar kullanmak gibi basit adımlar, vücudumuza giren mikroplastik miktarını önemli ölçüde azaltabilir.
- Popüler Haberler -
Kardiyologlardan kalp krizi riskini azaltan öneriler
Gece yeme sendromu uyku kalitesini nasıl etkiliyor?
Kardiyologdan sabah kahvesi uyarısı! Aç karnına risk artıyor
Böbrek dostu gıdalar açıklandı! 8 besinle sağlığınızı koruyun
Uzmanlardan karaciğer sağlığı uyarısı! Bu 4 takviye risk taşıyor
Sağlık Bakanı Memişoğlu: ASELSAN'ın Lifeline HLM Makinesi ilk kez kullanıldı



